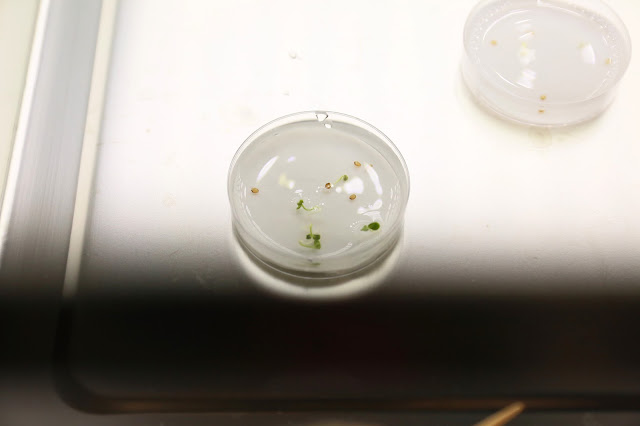

Happy Sunday,在分享更多的團年飯/賀年糕點前,今天補記上週六帶小兄妹參加 美國冒險樂園-都市小農夫 x JP Garden 的清新美好體驗!
「都市小農夫」大概內容,可能大家由早前 一樓咖啡廳 的博文也有輕微了解過,其實整個體驗還要細緻很多、很多,當中很多內容連成人也未必知道,卻全被爸爸細心記錄下來了。這是甜魔媽媽非常喜歡的一段片子,非常推介大家一看啊~
看了爸爸的影片後,應該大家對整個行程及課堂內容都了解清楚了,下面媽媽只補上簡單圖文就好!還記得去年暑期入住 九龍君綽酒店 時,已想帶小兄妹來黃埔新天地聚寶坊玩樂;現在港鐵通車了,來黃埔無疑更方便了~
美國冒險樂園黃埔總店很大,除了玩樂設施,又有都市小農夫 x JP Garden、韓國 Misulo 幼兒探索課程、烘焙教室等等體驗館,寓娛樂、學習及實踐於一身。其中都市小農夫一進樂園就可見到,店內一片青綠讓人看得很舒服呢!
企理環境及專業配套下,「都市小農夫」課程卻不算貴,會員可享三堂優惠價$300,完成後更有證書頒發。抵達後去個洗手間(樂園有洗手間很方便小孩),清潔好雙手,也是時間穿上圍裙、又穿上鞋套,要拿護照「嘟」入無菌室了!同行大人也要穿鞋套哦~
經過無菌室前,還要先經風機吹走身上細菌。這個裝置甜魔媽媽曾在參觀 奇華餅房 時,帶Chloe妹妹體驗過(那邊更嚴謹還要載上頭套);Matthew卻是首次經歷,感覺十分新奇!
來到無菌水耕種植室了!可能大家也與甜魔媽媽有疑問:為什麼要水耕?好處是甚麼?原來在無泥土的情況下加上無菌裝置,可輕易阻隔細菌/昆蟲對植物的侵害;而室內種種高科技日照/紅藍燈/濕度控制儀器,也令植物的成長免受天氣反覆影響。
以下是一些區內水耕的植物,只要在水中補充適當的營養液,以模仿泥土的營養成分,植物就成健康茁壯成長了!
我們體驗的是濃縮版課程,第一堂主要是:讓小朋友透過儀器觀察種子,以及讓小朋友嘗試種植(落種),下圖職員一邊介紹種子、一邊教導小兄妹使用顯微鏡,讓他們提升觀察力及探索能力。
兩兄妹都給發獲一包10粒的小種子,二人要將種子由包裝袋取出,然後加水浸泡,再之後倒進試管中並封好。過程都幾考驗小手肌的運用呢!
然後是「喚醒」種子的重要步驟:將滿載種子的試管放進溫水機內浸個「暖水 Spa」,以春化作用來提示種子要開始發芽了!溫度與我們浸浴相約,都是40度左右,過程要15分鐘。
種子嘆 Spa 時間,我們去參觀/認識/觸模其他植物,同時一邊講解水耕種植生長過程及根部生長重要性。小朋友有機會拿出植物查看根部,並比較不同植物的根部特點;甜魔媽媽也是這天才知,原來菜類的根部比花類的根部要簡單些!
小種子經過春化作用及浸泡,在適當日照及溫度下,約2-3天就會開始發芽。第二堂就是開始種植小芽;見到碟內的新芽及種子舊殻嗎?全是非常細小,但小兄妹要用鉗子,細心將之搬到「新家」小海綿中間;過程又是非常考小手肌運用,而兩兄妹都做得非常好!
由於根部有向水性,當成功「移苗」後,小朋友還要用手將海綿多餘的水擠掉,讓種子根部乖乖向下生長。好不容易又完成後,兩兄妹都紛紛露出鬼馬的笑容!
早前提到水耕植物要添加營養液,這天Matthew就幫忙將加了A, B 營養液的水倒進盤底,讓新苗努力吸引。之後還會有儀器量度水的 PH 植等等!
去到第三堂時,新芽應該已發芽成健康幼苗,可以拿出無菌室、加上泥土讓小學員帶回家繼續種植了!而課程也會按小朋友的程度,繼續講及向光素(高瘦藍光)及光敏素(矮胖紅光),還有更多光線強弱對植物的影響,等等。
而對小兄妹來講,更興奮是之後到美國冒險樂園任玩大型機動遊戲!每節遊戲收費50代幣,場內設$120/5張套票,但最抵是參加 DIY 任玩派對,包 DIY 盆景製作 (價值$168)、JP Garden 派對區1.5小時,以及全日任玩,每位小朋友不過$200(10位起)。
兩兄妹先玩了青蛙笨豬跳,由照片可見Matthew一臉期待及興奮,而Chloe其實有點驚驚豬,但也忍住了沒哭沒叫,十分叻叻!
又玩了迷你摩天輪(這個畏高爸爸都不怕,哈),以及180度旋轉、有點刺激的海盜船,這次Chloe忍不住將小臉緊貼爸爸了!
我們還玩了卡通搖擺車、轉轉杯,以及最受較大小朋友喜愛的碰碰車,一家人特別是Matthew情緒興奮不得了~
之不過,估你唔到全場最刺激的,是這彈跳飛車,那一升一降幅度不是講笑,一定要扣好安全帶,否則有機會彈出車外!
玩完機動遊戲,小兄妹又到佔地1/3的升級巨無霸迷宮玩樂(收費75代幣/2張遊戲劵),而且一玩就是2節!直到又累又餓,才忍不住要跑出來找吃的~
提起吃,這烘焙教室在三間體驗館中面積最大,以夢幼糖果屋為主題十分吸引,小朋友參加後也有證書頒發!不過遠「餅」不能救近「餓」,在樓上分享一份開心樂園餐後,兩兄妹又回到 JP Garden 參加 DIY 盆景製作。
盆景製作過程,是按步驟舖上陶土粒、泥層,然後放進自選的迷你盆景植物,再加上自選彩砂、小裝飾而成,收費 package 由$138起。
在專人指導下,小盆景很快就完成了,當然要來張合照啦!連同早日「春化作用」喚醒的種子入土,又有重甸甸的收穫帶走。要讚職員非常細心,知道我們晚上有約,特別放置額外空氣棒,又送上額外彩砂,讓我們回家也可為盆景「補妝」。
很好玩又有意義的一次體驗,謝謝美國冒險樂園的邀請,讓兩兄妹過了超滿足的一個下午。相信我們不久後又會再來玩了!
美國冒險樂園 都市小農夫 x JP Garden
地址:紅磡德康街6號黃埔新天地聚寶坊
Facebook:美國冒險樂園 都市小農夫 X JPGarden

印象中我第一次接觸顯微鏡已經係中學嘅lab啦,依家嘅小朋友真係多好多唔同途徑嘅學習機會,最正係學習完仲有得去冒險樂園到冒險嘛!;P
回覆刪除正解,兩兄妹一開始已經好心急想去玩啦
刪除但個課程真係設計得好好,唔好話MC,我自己都學了唔少野
現在的冒險樂園內容很豐富啊~
回覆刪除依家小朋友邊似我地細個咁單純,所以內容全部提昇哂呢
刪除